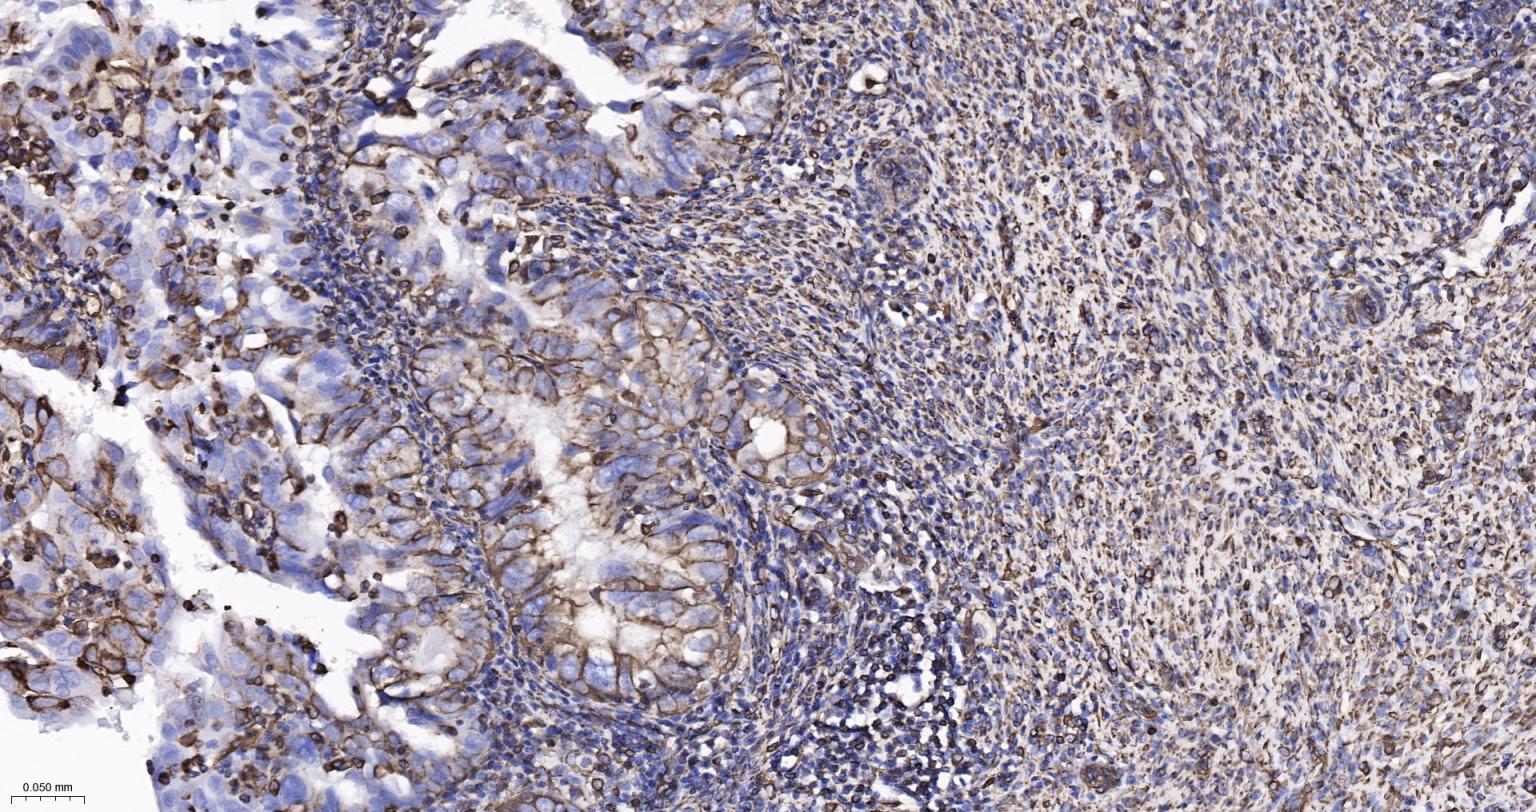
波形蛋白重组兔单抗-bsm-63101R
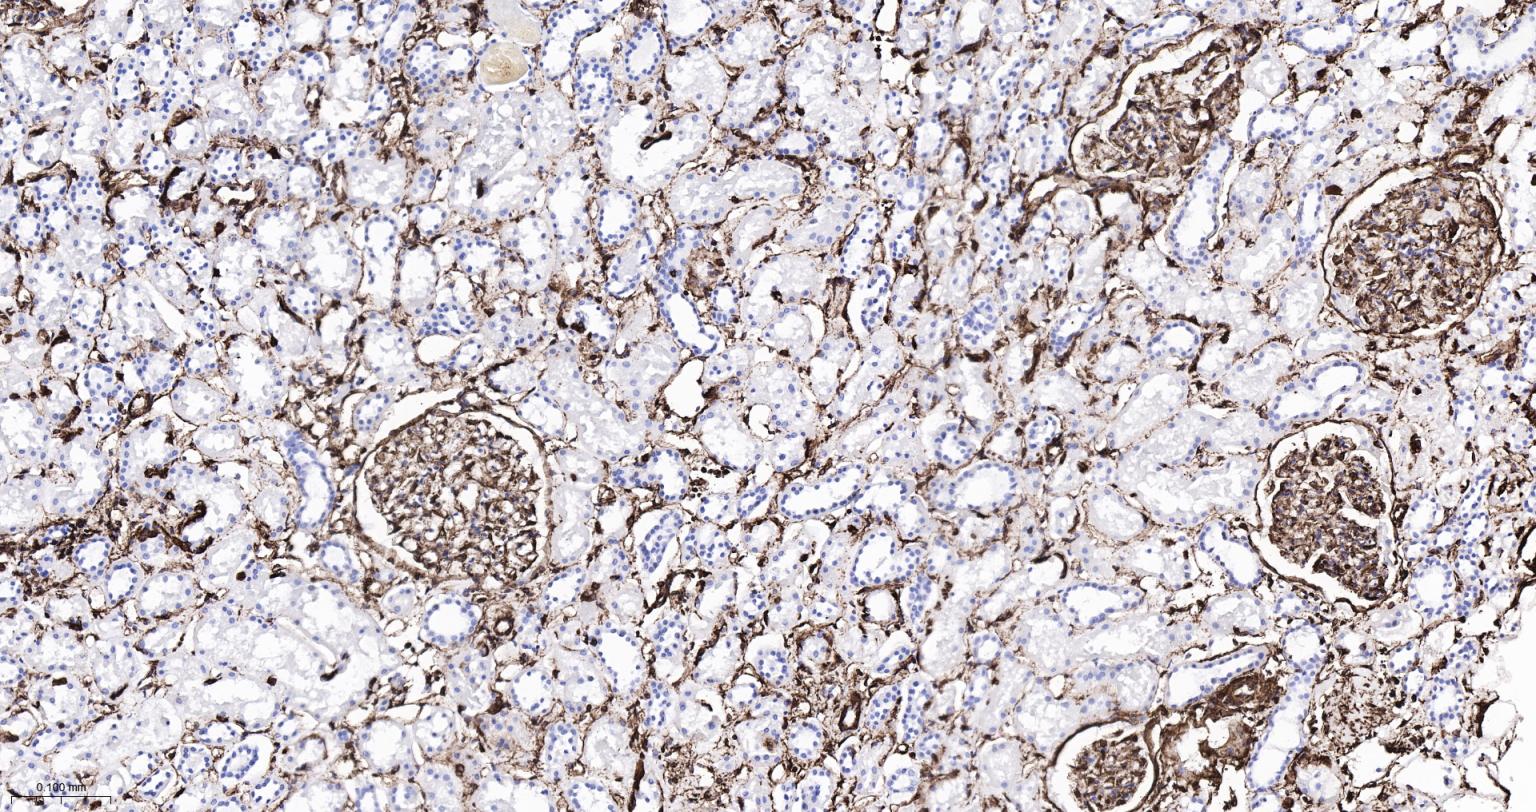
波形蛋白重组兔单抗-bsm-63101R

Vimentin Recombinant Rabbit mAb (一抗) - WB,IHC-P,IHC-F,IF,Flow-Cyt,ICC/IF | Bioss
Rrmab?兔单抗

货号:bsm-63101R
产品详情
相关标记
相关产品
相关文献
常见问题
概述
产品编号
bsm-63101R
产品类型
重组兔单抗、mIHC精品抗体
英文名称
Vimentin Recombinant Rabbit mAb
中文名称
波形蛋白重组兔单抗
英文别名
VIME_HUMAN; VIM; VIME_MOUSE; VIME_RAT; vimentin
抗体来源
Rabbit
免疫原
A synthesized peptide derived from human Vimentin: 405-466
亚型
IgG
性状
Liquid
纯化方法
affinity purified by Protein A
克隆类型
Recombinant
克隆号
4E11
理论分子量
54 kDa
检测分子量
54 kDa
储存液
10mM phosphate buffered saline(pH 7.4) with 150mM sodium chloride, 0.05% BSA, 0.02% Proclin300 and 50% glycerol.
研究领域
Developmental Biology > Lineage specification > Ectoderm
Neuroscience > Cell Type Marker > Neural Stem Cell marker
Neuroscience > Neurology process > Neurogenesis
Neuroscience > Neurology process > Neuroregeneration > Neuroregeneration
Signal Transduction > Antibodies > vimentin
Signal Transduction > Cytoskeleton / ECM > Cytoskeleton > Intermediate Filaments > Class III > Vimentin
SWISS
Gene ID
保存条件
Store at 4℃ for short term. Store at -20℃ for long term. Avoid repeated freeze/thaw cycles.
注意事项
This product as supplied is intended for research use only, not for use in human, therapeutic or diagnostic applications.
数据库链接
产品介绍
背景资料
Vimentins are class-III intermediate filaments found in various non-epithelial cells, especially mesenchymal cells. Vimentin is attached to the nucleus, endoplasmic reticulum, and mitochondria, either laterally or terminally. Involved with LARP6 in the stabilization of type I collagen mRNAs for CO1A1 and CO1A2.

产品应用
| 应用 | 已检合格种属 | 预测种属 | 推荐稀释比例 |
|---|---|---|---|
| WB | Human, Mouse, Rat | 1:500-2000 | |
| IHC-P | Human, Mouse, Rat | 1:100-500 | |
| IHC-F | Human, Mouse, Rat | 1:100-500 | |
| IF | Human, Mouse, Rat | 1:100-500 | |
| Flow-Cyt | Human | Mouse, Rat | 1:50-100 |
| ICC/IF | Human | Mouse, Rat | 1:100-500 |
交叉反应
交叉反应: Human, Mouse, Rat
相关产品
暂无相关产品
靶标
基因名
VIM
蛋白名
Vimentin
亚基
Homopolymer assembled from elementary dimers. Interacts with HCV core protein. Interacts with LGSN and SYNM. Interacts (via rod region) with PLEC (via CH 1 domain) (By similarity). Interacts with SLC6A4. Interacts with STK33. Interacts with LARP6. Interacts with RAB8B (By similarity).
亚细胞定位
Cytoplasm.
组织特异性
Highly expressed in fibroblasts, somev expression in T- and B-lymphocytes, and little or no expression in Burkitt's lymphoma cell lines. Expressed in many hormone-independent mammary carcinoma cell lines.
翻译后修饰
Filament disassembly during mitosis is promoted by phosphorylation at Ser-55 as well as by nestin (By similarity). One of the most prominent phosphoproteins in various cells of mesenchymal origin. Phosphorylation is enhanced during cell division, at which time vimentin filaments are significantly reorganized. Phosphorylation by PKN1 inhibits the formation of filaments. Phosphorylated at Ser-56 by CDK5 during neutrophil secretion in the cytoplasm. Phosphorylated by STK33.
疾病
Cataract 30 (CTRCT30)
The disease is caused by mutations affecting the gene represented in this entry.
Disease description:An opacification of the crystalline lens of the eye that frequently results in visual impairment or blindness. Opacities vary in morphology, are often confined to a portion of the lens, and may be static or progressive. In general, the more posteriorly located and dense an opacity, the greater the impact on visual function.
The disease is caused by mutations affecting the gene represented in this entry.
Disease description:An opacification of the crystalline lens of the eye that frequently results in visual impairment or blindness. Opacities vary in morphology, are often confined to a portion of the lens, and may be static or progressive. In general, the more posteriorly located and dense an opacity, the greater the impact on visual function.
相似性
Belongs to the intermediate filament family.
功能
Vimentins are class-III intermediate filaments found in various non-epithelial cells, especially mesenchymal cells. Vimentin is attached to the nucleus, endoplasmic reticulum, and mitochondria, either laterally or terminally.
Involved with LARP6 in the stabilization of type I collagen mRNAs for CO1A1 and CO1A2.
Involved with LARP6 in the stabilization of type I collagen mRNAs for CO1A1 and CO1A2.
同靶标产品
相关文献
提示: 发表研究结果有使用 bsm-63101R 时请让我们知道,以便我们可以引用参考文章。作为回馈,资料提供者将获得我们送上的小礼品。